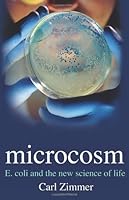

Microcosm E Coli And The New Science Of Life
[PDF] Microcosm E Coli And The New Science Of Life Ebook
Book Review Microcosm E Coli And The New Science Of
Book Review Microcosm E Coli And The New Science Of

Microcosm E Coli And The New Science Of Life By Carl
Microcosm E Coli And The New Science Of Life By Carl
Microcosm E Coli And The New Science Of Life By Carl Zimmer
Microcosm E Coli And The New Science Of Life By Carl Zimmer

Microcosm By Carl Zimmer Penguin Books Australia
Microcosm By Carl Zimmer Penguin Books Australia

Microcosm E Coli And The New Science Of Life By Carl Zimmer
Microcosm E Coli And The New Science Of Life By Carl Zimmer

Microcosm E Coli And The New Science Of Life By Carl Zimmer
Microcosm E Coli And The New Science Of Life By Carl Zimmer
0 Response to "Microcosm E Coli And The New Science Of Life"
Post a Comment